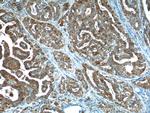
Galectin-3 Antibody in Immunohistochemistry (Paraffin) (IHC (P))
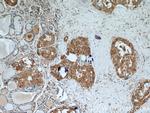
Galectin-3 Antibody in Immunohistochemistry (Paraffin) (IHC (P))

Search
Proteintech
Galectin-3 Polyclonal Antibody
{{$productOrderCtrl.translations['antibody.pdp.commerceCard.promotion.promotions']}}
{{$productOrderCtrl.translations['antibody.pdp.commerceCard.promotion.viewpromo']}}
{{$productOrderCtrl.translations['antibody.pdp.commerceCard.promotion.promocode']}}: {{promo.promoCode}} {{promo.promoTitle}} {{promo.promoDescription}}. {{$productOrderCtrl.translations['antibody.pdp.commerceCard.promotion.learnmore']}}
产品信息
14979-1-AP
种属反应
已发表种属
宿主/亚型
分类
类型
抗原
偶联物
形式
浓度
规格
纯化类型
保存液
内含物
保存条件
运输条件
产品详细信息
Immunogen sequence: MADNFSLHD ALSGSGNPNP QGWPGAWGNQ PAGAGGYPGA SYPGAYPGQA PPGAYPGQAP PGAYPGAPGA YPGAPAPGVY PGPPSGPGAY PSSGQPSATG AYPATGPYGA PAGPLIVPYN LPLPGGVVPR MLITILGTVK PNANRIALDF QRGNDVAFHF NPRFNENNRR VIVCNTKLDN NWGREERQSV FPFESGKPFK IQVLVEPDHF KVAVNDAHLL QYNHRVKKLN EISKLGISGD IDLTSASYTM I (1-250 aa encoded by BC001120)
靶标信息
Galactose-specific lectin which binds IgE. May mediate with the alpha-3, beta-1 integrin the stimulation by CSPG4 of endothelial cells migration. Together with DMBT1, required for terminal differentiation of columnar epithelial cells during early embryogenesis. In the nucleus: acts as a pre-mRNA splicing factor. Involved in acute inflammatory responses including neutrophil activation and adhesion, chemoattraction of monocytes macrophages, opsonization of apoptotic neutrophils, and activation of mast cells.
仅用于科研。不用于诊断过程。未经明确授权不得转售。
生物信息学
蛋白别名: 35 kDa lectin; advanced glycation end-product receptor 3; Carbohydrate-binding protein 35; CBP 35; CBP-30; epididymis secretory sperm binding protein; epithelial-specific lectin; epsilon BP; Gal-3; Galactose-specific lectin 3; Galactoside-binding protein; GALBP; Galectin-3; Galectin3; IgE binding protein; IgE-binding protein; L-29; L-31; L-34 galactoside-binding lectin; Laminin-binding protein; lectin galactoside-binding soluble 3 protein; Lectin L-29; lectin, galactose binding, soluble 3; lectin, galactoside-binding, soluble, 3; LGALS3; MAC-2 antigen; unnamed protein product
基因别名: AGE-R3; CBP30; CBP35; gal-3; GAL3; GALBP; GALIG; GBP; L-34; L31; LGALS2; LGALS3; Mac-2; MAC2
UniProt ID: (Human) P17931, (Rat) P08699
Entrez Gene ID: (Human) 3958, (Mouse) 16854, (Rat) 83781